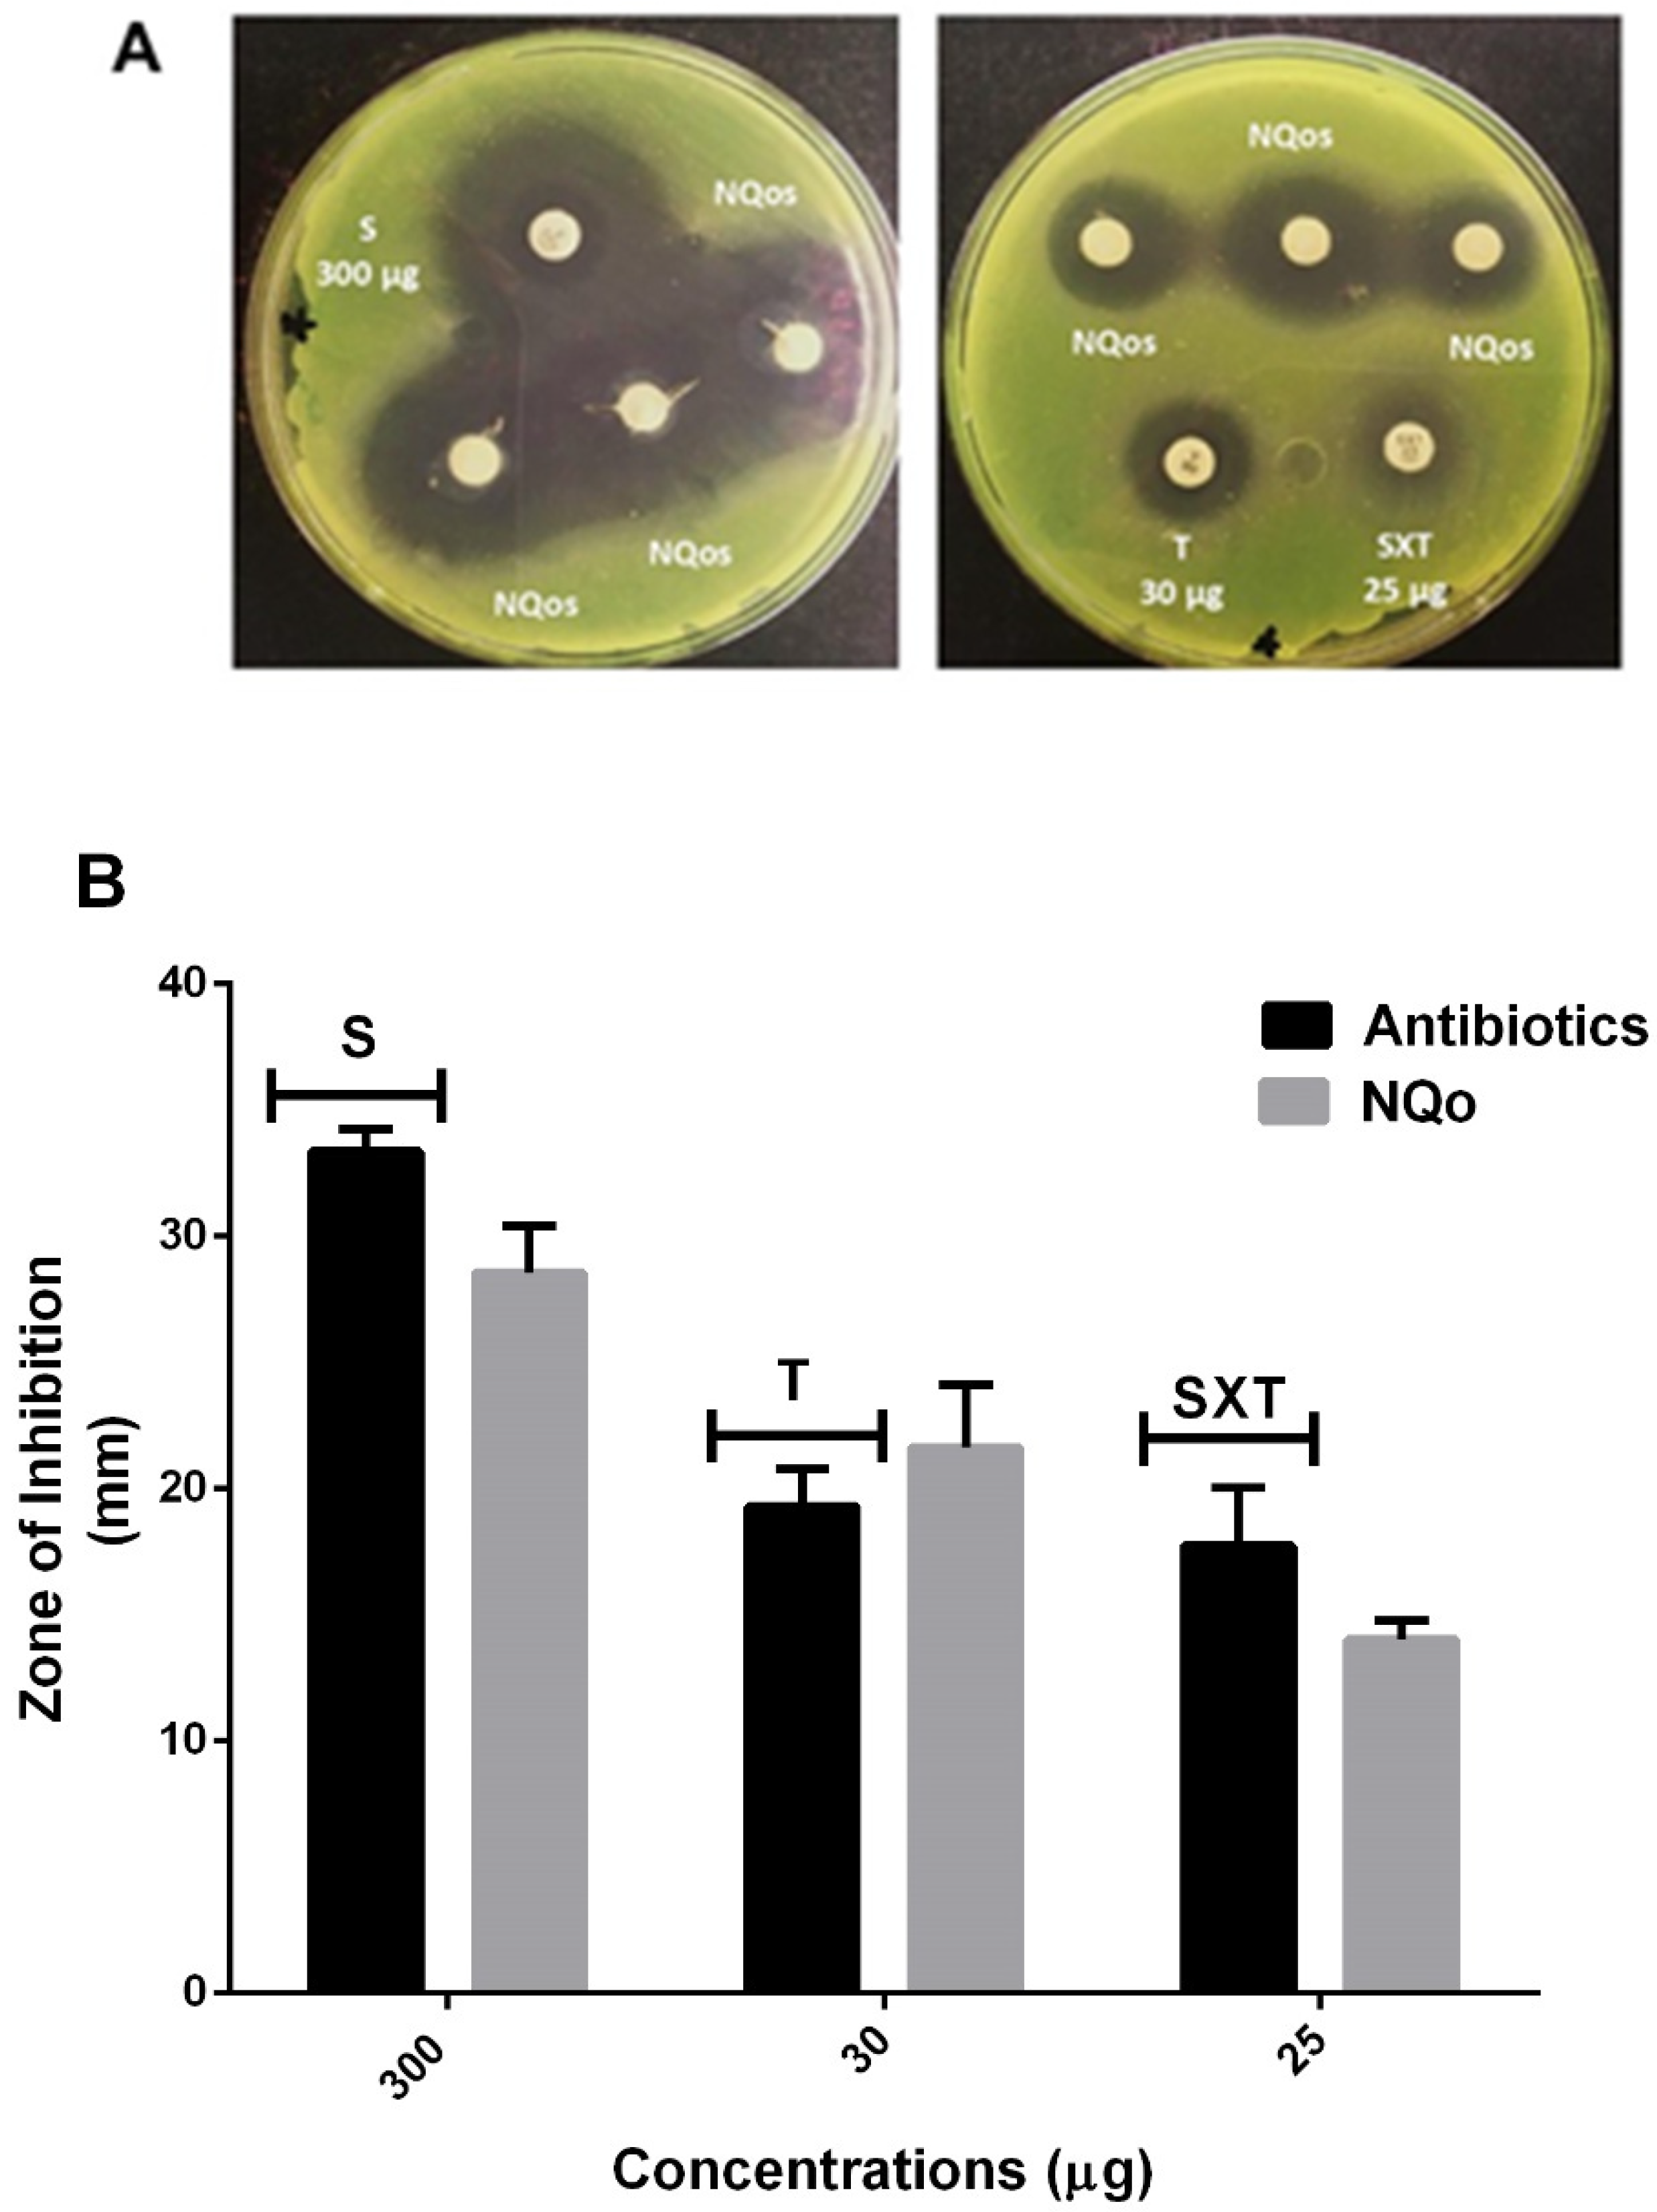

Antimicrobial and Antibiofilm Capacity of Chitosan Nanoparticles against Wild Type Strain of Pseudomonas sp. Isolated from Milk of Cows Diagnosed with Bovine Mastitis
Abstract
1. Introduction
2. Results
2.1. Characterization of Chitosan Nanoparticles (NQo)
2.2. Antimicrobial Capacity of NQo
2.2.1. Minimum Inhibitory Concentration and Minimum Bactericidal Concentration
2.2.2. Disk Diffusion Test and Comparison of NQo to Conventional Antibiotics
2.2.3. Antibiofilm Capacity of NQo
3. Discussion
3.1. Characterization of NQo
3.2. Antimicrobial Capacity of NQo
3.3. Biofilm Inhibition Properties of NQo
3.4. Eradication of NQo to Established Mature Pseudomonas sp. Biofilm and Phenotype Recovery
4. Materials and Methods
4.1. Bacterial Strain, Isolation and Culture Conditions
4.2. Synthesis of Chitosan Nanoparticles (NQo)
4.3. Characterization of NQo
4.3.1. Cinematic Viscosity Determination
4.3.2. Surface Tension Measurements
4.3.3. Determination of Size, Z Potential and Polydispersity Index
4.3.4. Transmission Electron Microscopy (TEM)
4.4. Determination of Minimum Inhibitory Concentration (MIC) and Minimum Bactericidal Concentrations (MBC) of NQo
4.5. Disk Diffusion Test and Comparison of NQo to Conventional Antibiotics
4.6. Evaluation of Biofilm Inhibition and Eradication Properties of NQo
4.6.1. Biofilm Inhibition by NQo
4.6.2. Mature Biofilm Eradication and Recovery of the Phenotype
4.7. Statistical Analysis
5. Conclusions
Author Contributions
Funding
Acknowledgments
Conflicts of Interest
References
- Martins, S.A.M.; Martins, V.C.; Cardoso, F.A.; Germano, J.; Rodrigues, M.; Duarte, C.; Bexiga, R.; Cardoso, S.; Freitas, P.P. Biosensors for on-farm diagnosis of mastitis. Front. Bioeng. Biotechnol. 2019, 7. [Google Scholar] [CrossRef] [PubMed]
- Ruegg, P.L. A 100-Year Review: Mastitis detection, management, and prevention. J. Dairy Sci. 2017, 100, 10381–10397. [Google Scholar] [CrossRef] [PubMed]
- Aslantaş, Ö.; Demir, C. Investigation of the antibiotic resistance and biofilm-forming ability of Staphylococcus aureus from subclinical bovine mastitis cases. J. Dairy Sci. 2016, 99, 8607–8613. [Google Scholar] [CrossRef]
- Fessia, A.S.; Dieser, S.A.; Raspanti, C.G.; Odierno, L.M. Genotyping and study of adherence-related genes of Streptococcus uberis isolates from bovine mastitis. Microb. Pathog. 2019, 130, 295–301. [Google Scholar] [CrossRef] [PubMed]
- Angelopoulou, A.; Holohan, R.; Rea, M.C.; Warda, A.K.; Hill, C.; Ross, R.P. Bovine mastitis is a polymicrobial disease requiring a polydiagnostic approach. Int. Dairy J. 2015, 99, 104539. [Google Scholar] [CrossRef]
- Klaas, I.C.; Zadoks, R.N. An update on environmental mastitis: Challenging perceptions. Transbound. Emerg. Dis. 2018, 65, 166–185. [Google Scholar] [CrossRef]
- Schukken, Y.; Chuff, M.; Moroni, P.; Gurjar, A.; Santisteban, C.; Welcome, F.; Zadoks, R. The “Other” Gram-Negative Bacteria in Mastitis. Klebsiella, Serratia, and More. Vet. Clin. N. Am. Food Anim. Pract. 2012, 28, 239–256. [Google Scholar] [CrossRef]
- Meng, L.; Zhang, Y.; Liu, H.; Zhao, S.; Wang, J.; Zheng, N. Characterization of Pseudomonas spp. and associated proteolytic properties in raw milk stored at low temperatures. Front. Microbiol. 2017, 8, 1–7. [Google Scholar] [CrossRef]
- Park, H.; Hong, M.; Hwang, S.; Park, Y.; Kwon, K.; Yoon, J.; Shin, S.; Kim, J.; Park, Y. Characterisation of Pseudomonas aeruginosa related to bovine mastitis. Acta Vet. Hung. 2014, 62, 1–12. [Google Scholar] [CrossRef]
- Bannerman, D.D.; Chockalingam, A.; Paape, M.J.; Hope, J.C. The bovine innate immune response during experimentally-induced Pseudomonas aeruginosa mastitis. Vet. Immunol. Immunopathol. 2005, 107, 201–215. [Google Scholar] [CrossRef]
- Kelly, E.J.; Wilson, D.J. Pseudomonas aeruginosa mastitis in two goats associated with an essential oil–based teat dip. J. Vet. Diagn. Investig. 2016, 28, 760–762. [Google Scholar] [CrossRef]
- McDougall, S.; Arthur, D.G.; Bryan, M.A.; Vermunt, J.J.; Weir, A.M. Clinical and bacteriological response to treatment of clinical mastitis with one of three intramammary antibiotics. N. Z. Vet. J. 2007, 55, 161–170. [Google Scholar] [CrossRef] [PubMed]
- Vidal, A.M.C.; Netto, A.S.; Vaz, A.C.N.; Capodifóglio, E.; Gonçalves, A.C.S.; Rossi, G.A.M.; Figueiredo, A.S.; Ruiz, V.L.A. Pseudomonas spp.: Contamination sources in bulk tanks of dairy farms. Pesqui. Vet. Bras. 2017, 37, 941–948. [Google Scholar] [CrossRef]
- Bassetti, M.; Vena, A.; Croxatto, A.; Righi, E.; Guery, B. How to manage Pseudomonas aeruginosa infections. Drugs Context 2018, 7, 1–18. [Google Scholar] [CrossRef] [PubMed]
- Pang, Z.; Raudonis, R.; Glick, B.R.; Lin, T.J.; Cheng, Z. Antibiotic resistance in Pseudomonas aeruginosa: Mechanisms and alternative therapeutic strategies. Biotechnol. Adv. 2019, 37, 177–192. [Google Scholar] [CrossRef]
- Flemming, H.C.; Neu, T.R.; Wozniak, D.J. The EPS matrix: The “House of Biofilm Cells”. J. Bacteriol. 2007, 189, 7945–7947. [Google Scholar] [CrossRef]
- Moradali, M.F.; Ghods, S.; Rehm, B.H.A. Pseudomonas aeruginosa lifestyle: A paradigm for adaptation, survival, and persistence. Front. Cell. Infect. Microbiol. 2017, 7. [Google Scholar] [CrossRef]
- Kirchhelle, C. Pharming animals: A global history of antibiotics in food production (1935–2017). Palgrave Commun. 2018, 4. [Google Scholar] [CrossRef]
- Roy, R.; Tiwari, M.; Donelli, G.; Tiwari, V. Strategies for combating bacterial biofilms: A focus on anti-biofilm agents and their mechanisms of action. Virulence 2018, 9, 522–554. [Google Scholar] [CrossRef]
- Khan, F.; Pham, D.T.N.; Oloketuyi, S.F.; Manivasagan, P.; Oh, J.; Kim, Y.M. Chitosan and their derivatives: Antibiofilm drugs against pathogenic bacteria. Colloids Surf. B Biointerfaces 2020, 185, 110627. [Google Scholar] [CrossRef]
- Liaqat, F.; Eltem, R. Chitooligosaccharides and their biological activities: A comprehensive review. Carbohydr. Polym. 2018, 184, 243–259. [Google Scholar] [CrossRef] [PubMed]
- Youssef, A.M.; Abou-Yousef, H.; El-Sayed, S.M.; Kamel, S. Mechanical and antibacterial properties of novel high performance chitosan/nanocomposite films. Int. J. Biol. Macromol. 2015, 76, 25–32. [Google Scholar] [CrossRef] [PubMed]
- Najafabadi, S.A.A.; Mohammadi, A.; Kharazi, A.Z. Polyurethane nanocomposite impregnated with chitosan-modified graphene oxide as a potential antibacterial wound dressing. Mater. Sci. Eng. C 2020, 110899. [Google Scholar] [CrossRef] [PubMed]
- Xie, M.; Huang, K.; Yang, F.; Wang, R.; Han, L.; Yu, H.; Ye, Z.; Wu, F. Chitosan nanocomposite films based on halloysite nanotubes modification for potential biomedical applications. Int. J. Biol. Macromol. 2020, 151, 1116–1125. [Google Scholar] [CrossRef] [PubMed]
- Khan, F.; Manivasagan, P.; Lee, J.W.; Pham, D.T.N.; Oh, J.; Kim, Y.M. Fucoidan-stabilized gold nanoparticle-mediated biofilm inhibition, attenuation of virulence and motility properties in Pseudomonas aeruginosa PAO1. Mar. Drugs 2019, 17, 208. [Google Scholar] [CrossRef]
- Paomephan, P.; Assavanig, A.; Chaturongakul, S.; Cady, N.C.; Bergkvist, M.; Niamsiri, N. Insight into the antibacterial property of chitosan nanoparticles against Escherichia coli and Salmonella Typhimurium and their application as vegetable wash disinfectant. Food Control 2018, 86, 294–301. [Google Scholar] [CrossRef]
- Huang, J.; Liu, Y.; Yang, L.; Zhou, F. Synthesis of sulfonated chitosan and its antibiofilm formation activity against E. coli and S. aureus. Int. J. Biol. Macromol. 2019, 129, 980–988. [Google Scholar] [CrossRef]
- Shah, A.; Ashames, A.A.; Buabeid, M.A.; Murtaza, G. Synthesis, in vitro characterization and antibacterial efficacy of moxifloxacin-loaded chitosan-pullulan-silver-nanocomposite films. J. Drug Deliv. Sci. Technol. 2020, 55. [Google Scholar] [CrossRef]
- Muslim, S.N.; Kadmy, I.M.S.A.; Ali, A.N.M.; Salman, B.K.; Ahmad, M.; Khazaal, S.S.; Hussein, N.H.; Muslim, S.N. Chitosan extracted from Aspergillus flavus shows synergistic effect, eases quorum sensing mediated virulence factors and biofilm against nosocomial pathogen Pseudomonas aeruginosa. Int. J. Biol. Macromol. 2018, 107, 52–58. [Google Scholar] [CrossRef]
- Kaur, P.; Choudhary, A.; Thakur, R. Synthesis of chitosan-silver nanocomposites and their antibacterial activity. Int. J. Sci. Eng. Res. 2013, 4, 869. [Google Scholar]
- Wang, W.; Arshad, M.I.; Khurshid, M.; Rasool, M.H.; Nisar, M.A.; Aslam, M.A.; Qamar, M.U. Antibiotic resistance: A rundown of a global crisis. Infect. Drug Resist. 2018, 11, 1645–1658. [Google Scholar]
- Orellano, M.S.; Isaac, P.; Breser, M.L.; Bohl, L.P.; Conesa, A.; Falcone, R.D.; Porporatto, C. Chitosan nanoparticles enhance the antibacterial activity of the native polymer against bovine mastitis pathogens. Carbohydr. Polym. 2019, 213, 1–9. [Google Scholar] [CrossRef] [PubMed]
- Caro, N.; Medina, E.; Díaz-Dosque, M.; López, L.; Abugoch, L.; Tapia, C. Novel active packaging based on films of chitosan and chitosan/quinoa protein printed with chitosan-tripolyphosphate-thymol nanoparticles via thermal ink-jet printing. Food Hydrocoll. 2016, 52, 520–532. [Google Scholar] [CrossRef]
- Yue, Y.; Kan, Y.; Choi, H.; Clearfield, A.; Liang, H. Correlating hydrodynamic radii with that of two dimensional nanoparticles. Appl. Phys. Lett. 2015, 107. [Google Scholar] [CrossRef]
- Stetefeld, J.; McKenna, S.A.; Patel, T.R. Dynamic light scattering: A practical guide and applications in biomedical sciences. Biophys. Rev. 2016, 8, 409–427. [Google Scholar] [CrossRef]
- Medina, E.; Caro, N.; Abugoch, L.; Gamboa, A.; Díaz-Dosque, M.; Tapia, C. Chitosan thymol nanoparticles improve the antimicrobial effect and the water vapour barrier of chitosan-quinoa protein films. J. Food Eng. 2019, 240, 191–198. [Google Scholar] [CrossRef]
- Antoniou, J.; Liu, F.; Majeed, H.; Qi, J.; Yokoyama, W.; Zhong, F. Physicochemical and morphological properties of size-controlled chitosan-tripolyphosphate nanoparticles. Colloids Surf. A Physicochem. Eng. Asp. 2015, 465, 137–146. [Google Scholar] [CrossRef]
- Shaban, S.M.; Aiad, I.; El-Sukkary, M.M.; Soliman, E.A.; El-Awady, M.Y. Synthesis of newly cationic surfactant based on dimethylaminopropyl amine and their silver nanoparticles: Characterization; surface activity and biological activity. Chin. Chem. Lett. 2017, 28, 264–273. [Google Scholar] [CrossRef]
- Li, X.; Wang, R.; Shi, H.; Song, B. Effective surface tension of liquid marbles using controllable nanoparticle monolayers. Appl. Phys. Lett. 2018, 113. [Google Scholar] [CrossRef]
- Shaban, S.M.; Abd-Elaal, A.A. Studying the silver nanoparticles influence on thermodynamic behavior and antimicrobial activities of novel amide Gemini cationic surfactants. Mater. Sci. Eng. C 2017, 76, 871–885. [Google Scholar] [CrossRef]
- Kim, K.W.; Min, B.J.; Kim, Y.T.; Kimmel, R.M.; Cooksey, K.; Park, S.I. Antimicrobial activity against foodborne pathogens of chitosan biopolymer films of different molecular weights. LWT Food Sci. Technol. 2011, 44, 565–569. [Google Scholar] [CrossRef]
- Divya, K.; Vijayan, S.; George, T.K.; Jisha, M.S. Antimicrobial properties of chitosan nanoparticles: Mode of action and factors affecting activity. Fibers Polym. 2017, 18, 221–230. [Google Scholar] [CrossRef]
- Wang, L.; Hu, C.; Shao, L. The-antimicrobial-activity-of-nanoparticles--present-situation. Int. J. Nanomed. 2017, 12, 1227–1249. [Google Scholar] [CrossRef] [PubMed]
- Qi, L.; Xu, Z.; Jiang, X.; Hu, C.; Zou, X. Preparation and antibacterial activity of chitosan nanoparticles. Carbohydr. Res. 2004, 339, 2693–2700. [Google Scholar] [CrossRef] [PubMed]
- Felipe, V.; Breser, M.L.; Bohl, L.P.; Rodrigues da Silva, E.; Morgante, C.A.; Correa, S.G.; Porporatto, C. Chitosan disrupts biofilm formation and promotes biofilm eradication in Staphylococcus species isolated from bovine mastitis. Int. J. Biol. Macromol. 2019, 126, 60–67. [Google Scholar] [CrossRef]
- CLSI. Performance Standards for Antimicrobial Susceptibility Testing, 27th ed.; CLSI supplement M100; Clinical and Laboratory Standards Institute: Wayne, PA, USA, 2017. [Google Scholar]
- Demirci, H.; Murphy, F.; Murphy, E.; Gregory, S.T.; Dahlberg, A.E.; Jogl, G. A structural basis for streptomycin-induced misreading of the genetic code. Nat. Commun. 2013, 4. [Google Scholar] [CrossRef]
- Nguyen, F.; Starosta, A.L.; Arenz, S.; Sohmen, D.; Dönhöfer, A.; Wilson, D.N. Tetracycline antibiotics and resistance mechanisms. Biol. Chem. 2014, 395, 559–575. [Google Scholar] [CrossRef]
- Wei, C.; Ni, W.; Cai, X.; Zhao, J.; Cui, J. Evaluation of trimethoprim/sulfamethoxazole (SXT), minocycline, tigecycline, moxifloxacin, and ceftazidime alone and in combinations for sxt-susceptible and sxt-resistant stenotrophomonas maltophilia by in vitro time-kill experiments. PLoS ONE 2016, 11, e0152132. [Google Scholar] [CrossRef]
- Helander, I.M.; Nurmiaho-Lassila, E.L.; Ahvenainen, R.; Rhoades, J.; Roller, S. Chitosan disrupts the barrier properties of the outer membrane of Gram-negative bacteria. Int. J. Food Microbiol. 2001, 71, 235–244. [Google Scholar] [CrossRef]
- Liu, H.; Du, Y.; Wang, X.; Sun, L. Chitosan kills bacteria through cell membrane damage. Int. J. Food Microbiol. 2004, 95, 147–155. [Google Scholar] [CrossRef]
- Foster, L.J.R.; Ho, S.; Hook, J.; Basuki, M.; Marçal, H. Chitosan as a biomaterial: Influence of degree of deacetylation on its physiochemical, material and biological properties. PLoS ONE 2015, 10, e0135153. [Google Scholar] [CrossRef]
- Shrestha, A.; Zhilong, S.; Gee, N.K.; Kishen, A. Nanoparticulates for antibiofilm treatment and effect of aging on its antibacterial activity. J. Endod. 2010, 36, 1030–1035. [Google Scholar] [CrossRef] [PubMed]
- Joo, S.H.; Aggarwal, S. Factors impacting the interactions of engineered nanoparticles with bacterial cells and biofilms: Mechanistic insights and state of knowledge. J. Environ. Manag. 2018, 225, 62–74. [Google Scholar] [CrossRef]
- Khan, F.; Lee, J.W.; Manivasagan, P.; Pham, D.T.N.; Oh, J.; Kim, Y.M. Synthesis and characterization of chitosan oligosaccharide-capped gold nanoparticles as an effective antibiofilm drug against the Pseudomonas aeruginosa PAO1. Microb. Pathog. 2019, 135, 103623. [Google Scholar] [CrossRef] [PubMed]
- Flemming, H.C.; Wingender, J.; Szewzyk, U.; Steinberg, P.; Rice, S.A.; Kjelleberg, S. Biofilms: An emergent form of bacterial life. Nat. Rev. Microbiol. 2016, 14, 563–575. [Google Scholar] [CrossRef] [PubMed]
- Mellegard, H.; Strand, S.P.; Christensen, B.E.; Granum, P.E.; Hardy, S.P. Antibacterial activity of chemically defined chitosans: Influence of molecular weight, degree of acetylation and test organism. Int. J. Food Microbiol. 2011, 148, 48–54. [Google Scholar] [CrossRef]
- García-Lara, B.; Saucedo-Mora, M.A.; Roldán-Sánchez, J.A.; Pérez-Eretza, B.; Ramasamy, M.; Lee, J.; Coria-Jimenez, R.; Tapia, M.; Varela-Guerrero, V.; García-Contreras, R. Inhibition of quorum-sensing-dependent virulence factors and biofilm formation of clinical and environmental Pseudomonas aeruginosa strains by ZnO nanoparticles. Lett. Appl. Microbiol. 2015, 61, 299–305. [Google Scholar] [CrossRef]
- Franklin, M.J.; Nivens, D.E.; Weadge, J.T.; Lynne Howell, P. Biosynthesis of the Pseudomonas aeruginosa extracellular polysaccharides, alginate, Pel, and Psl. Front. Microbiol. 2011, 2, 1–16. [Google Scholar] [CrossRef]
- Wei, Q.; Ma, L.Z. Biofilm matrix and its regulation in Pseudomonas aeruginosa. Int. J. Mol. Sci. 2013, 14, 20983–21005. [Google Scholar] [CrossRef]
- Ayoub Moubareck, C.; Hammoudi Halat, D.; Akkawi, C.; Nabi, A.; AlSharhan, M.A.; AlDeesi, Z.O.; Peters, C.C.; Celiloglu, H.; Karam Sarkis, D. Role of outer membrane permeability, efflux mechanism, and carbapenemases in carbapenem-nonsusceptible Pseudomonas aeruginosa from Dubai hospitals: Results of the first cross-sectional survey. Int. J. Infect. Dis. 2019, 84, 143–150. [Google Scholar] [CrossRef]
- Da Costa Lima, J.L.; Alves, L.R.; Da Paz, J.N.P.; Rabelo, M.A.; Maciel, M.A.V.; De Morais, M.M.C. Analysis of biofilm production by clinical isolates of Pseudomonas aeruginosa from patients with ventilator-Associated pneumonia. Rev. Bras. Ter. Intensiva 2017, 29, 310–316. [Google Scholar] [CrossRef]
- Jiang, F.; Deng, Y.; Yeh, C.K.; Sun, Y. Quaternized chitosans bind onto preexisting biofilms and eradicate pre-attached microorganisms. J. Mater. Chem. B 2014, 2, 8518–8527. [Google Scholar] [CrossRef] [PubMed]
- Orgaz, B.; Lobete, M.M.; Puga, C.H.; Jose, C.S. Effectiveness of chitosan against mature biofilms formed by food related bacteria. Int. J. Mol. Sci. 2011, 12, 817–828. [Google Scholar] [CrossRef] [PubMed]
- Reighard, K.P.; Hill, D.B.; Dixon, G.A.; Worley, B.V.; Schoenfisch, M.H. Disruption and eradication of P. aeruginosa biofilms using nitric oxide-releasing chitosan oligosaccharides. Biofouling 2015, 31, 775–787. [Google Scholar] [CrossRef] [PubMed]
- Brindhadevi, K.; LewisOscar, F.; Mylonakis, E.; Shanmugam, S.; Verma, T.N.; Pugazhendhi, A. Biofilm and Quorum sensing mediated pathogenicity in Pseudomonas aeruginosa. Process Biochem. 2020, 96, 49–57. [Google Scholar] [CrossRef]
- Badawy, M.S.E.M.; Riad, O.K.M.; Taher, F.A.; Zaki, S.A. Chitosan and chitosan-zinc oxide nanocomposite inhibit expression of LasI and RhlI genes and quorum sensing dependent virulence factors of Pseudomonas aeruginosa. Int. J. Biol. Macromol. 2020, 149, 1109–1117. [Google Scholar] [CrossRef]
- Zhang, T.; Pabst, B.; Klapper, I.; Stewart, P.S. General theory for integrated analysis of growth, gene, and protein expression in biofilms. PLoS ONE 2013, 8, e83626. [Google Scholar] [CrossRef]
- Cornforth, D.M.; Dees, J.L.; Ibberson, C.B.; Huse, H.K.; Mathiesen, I.H.; Kirketerp-Møller, K.; Wolcott, R.D.; Rumbaugh, K.P.; Bjarnsholt, T.; Whiteley, M. Pseudomonas aeruginosa transcriptome during human infection. Proc. Natl. Acad. Sci. USA 2018, 115. [Google Scholar] [CrossRef]
- Han, C.; Goodwine, J.; Romero, N.; Steck, K.S.; Sauer, K.; Doiron, A. Enzyme-encapsulating polymeric nanoparticles: A potential adjunctive therapy in Pseudomonas aeruginosa biofilm-associated infection treatment. Colloids Surf. B Biointerfaces 2019, 184, 110512. [Google Scholar] [CrossRef]
- Valero-Leal, K.; Valbuena, E.; Chacón, F.; Olivares, Y.; Castro, G.; Briñez, W. Patógenos Contagiosos Y Ambientales Aislados De Cuartos Mamarios Con Mastitis Subclínica De Alto Riesgo En Tres Fincas Del Estado Zulia. Rev. Cient. Fac. Cienc. Vet. Univ. Zulia 2010, 20, 498–505. Available online: http://ve.scielo.org/scielo.php?script=sci_arttext&pid=S0798-22592010000500008&lng=es&tlng=es (accessed on 7 May 2020).
- Ramalho, R.; Cunha, J.; Teixeira, P.; Gibbs, P.A. Modified Pseudomonas agar: New differential medium for the detection/enumeration of Pseudomonas aeruginosa in mineral water. J. Microbiol. Methods 2002, 49, 69–74. [Google Scholar] [CrossRef]
- Augusto, C.; Escobar, M.; Vanessa, L.; Murillo, R.; Soto, J.F. Tecnologías Bioinformáticas para el Análisis de Secuencias de ADN Bioinformatics Technologies for the Analysis of DNA sequences. Sci. Tech. 2011, 49, 116–121. [Google Scholar]
- Limbago, B. M100-S11, Performance standards for antimicrobial susceptibility testing. Clin. Microbiol. Newsl. 2001, 23, 49. [Google Scholar] [CrossRef]
- Niederman, M.S. Antibiotic Use in the Mechanically Ventilated Patient. In Mechanical Ventilation: Clinical Applications and Pathophysiology, 1st ed.; Elsevier Inc.: Amsterdam, The Netherlands, 2008. [Google Scholar] [CrossRef]
- Hudzicki, J. Kirby-Bauer Disk Diffusion Susceptibility Test Protocol Author Information. American Society for Microbiology. December 2009, pp. 1–13. Available online: https://www.asm.org/Protocols/Kirby-Bauer-Disk-Diffusion-Susceptibility-Test-Pro (accessed on 22 July 2020).

| MIC NQo (µg/mL) | MBC NQo (µg/mL) | MBC/MIC |
|---|---|---|
| 280 | 700 | 2.5 |
| NQo (µg/mL) | Biofilm Inhibition (%) |
|---|---|
| 0 | 0 |
| 70 | 74.05 ± 0.83 |
| 140 | 73.28 ± 0.84 |
| 210 | 75.10 ± 0.65 |
| 280 | 88.96 ± 0.35 |
© 2020 by the authors. Licensee MDPI, Basel, Switzerland. This article is an open access article distributed under the terms and conditions of the Creative Commons Attribution (CC BY) license (http://creativecommons.org/licenses/by/4.0/).
Share and Cite
Rivera Aguayo, P.; Bruna Larenas, T.; Alarcón Godoy, C.; Cayupe Rivas, B.; González-Casanova, J.; Rojas-Gómez, D.; Caro Fuentes, N. Antimicrobial and Antibiofilm Capacity of Chitosan Nanoparticles against Wild Type Strain of Pseudomonas sp. Isolated from Milk of Cows Diagnosed with Bovine Mastitis. Antibiotics 2020, 9, 551. https://doi.org/10.3390/antibiotics9090551
Rivera Aguayo P, Bruna Larenas T, Alarcón Godoy C, Cayupe Rivas B, González-Casanova J, Rojas-Gómez D, Caro Fuentes N. Antimicrobial and Antibiofilm Capacity of Chitosan Nanoparticles against Wild Type Strain of Pseudomonas sp. Isolated from Milk of Cows Diagnosed with Bovine Mastitis. Antibiotics. 2020; 9(9):551. https://doi.org/10.3390/antibiotics9090551
Chicago/Turabian StyleRivera Aguayo, Paula, Tamara Bruna Larenas, Carlos Alarcón Godoy, Bernardita Cayupe Rivas, Jorge González-Casanova, Diana Rojas-Gómez, and Nelson Caro Fuentes. 2020. "Antimicrobial and Antibiofilm Capacity of Chitosan Nanoparticles against Wild Type Strain of Pseudomonas sp. Isolated from Milk of Cows Diagnosed with Bovine Mastitis" Antibiotics 9, no. 9: 551. https://doi.org/10.3390/antibiotics9090551
APA StyleRivera Aguayo, P., Bruna Larenas, T., Alarcón Godoy, C., Cayupe Rivas, B., González-Casanova, J., Rojas-Gómez, D., & Caro Fuentes, N. (2020). Antimicrobial and Antibiofilm Capacity of Chitosan Nanoparticles against Wild Type Strain of Pseudomonas sp. Isolated from Milk of Cows Diagnosed with Bovine Mastitis. Antibiotics, 9(9), 551. https://doi.org/10.3390/antibiotics9090551

